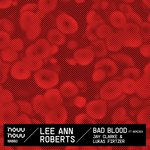

Bad Blood
Bad Blood

Reality Bytes (Balrog Remix)
Reality Bytes

Alter Ego (Tred Remix)
Alter Ego

O Come, O Come Emmanuel
Good People All, This Christmas Time

Ella Quiere (Party)
Ella Quiere (Party)

Alter Ego (Lokier Remix)
Alter Ego

Alter Ego (Milo Spykers Remix)
Alter Ego

What Child Is This?
Good People All, This Christmas Time

In the Past
Various Artists 02

O Holy Night
Good People All, This Christmas Time